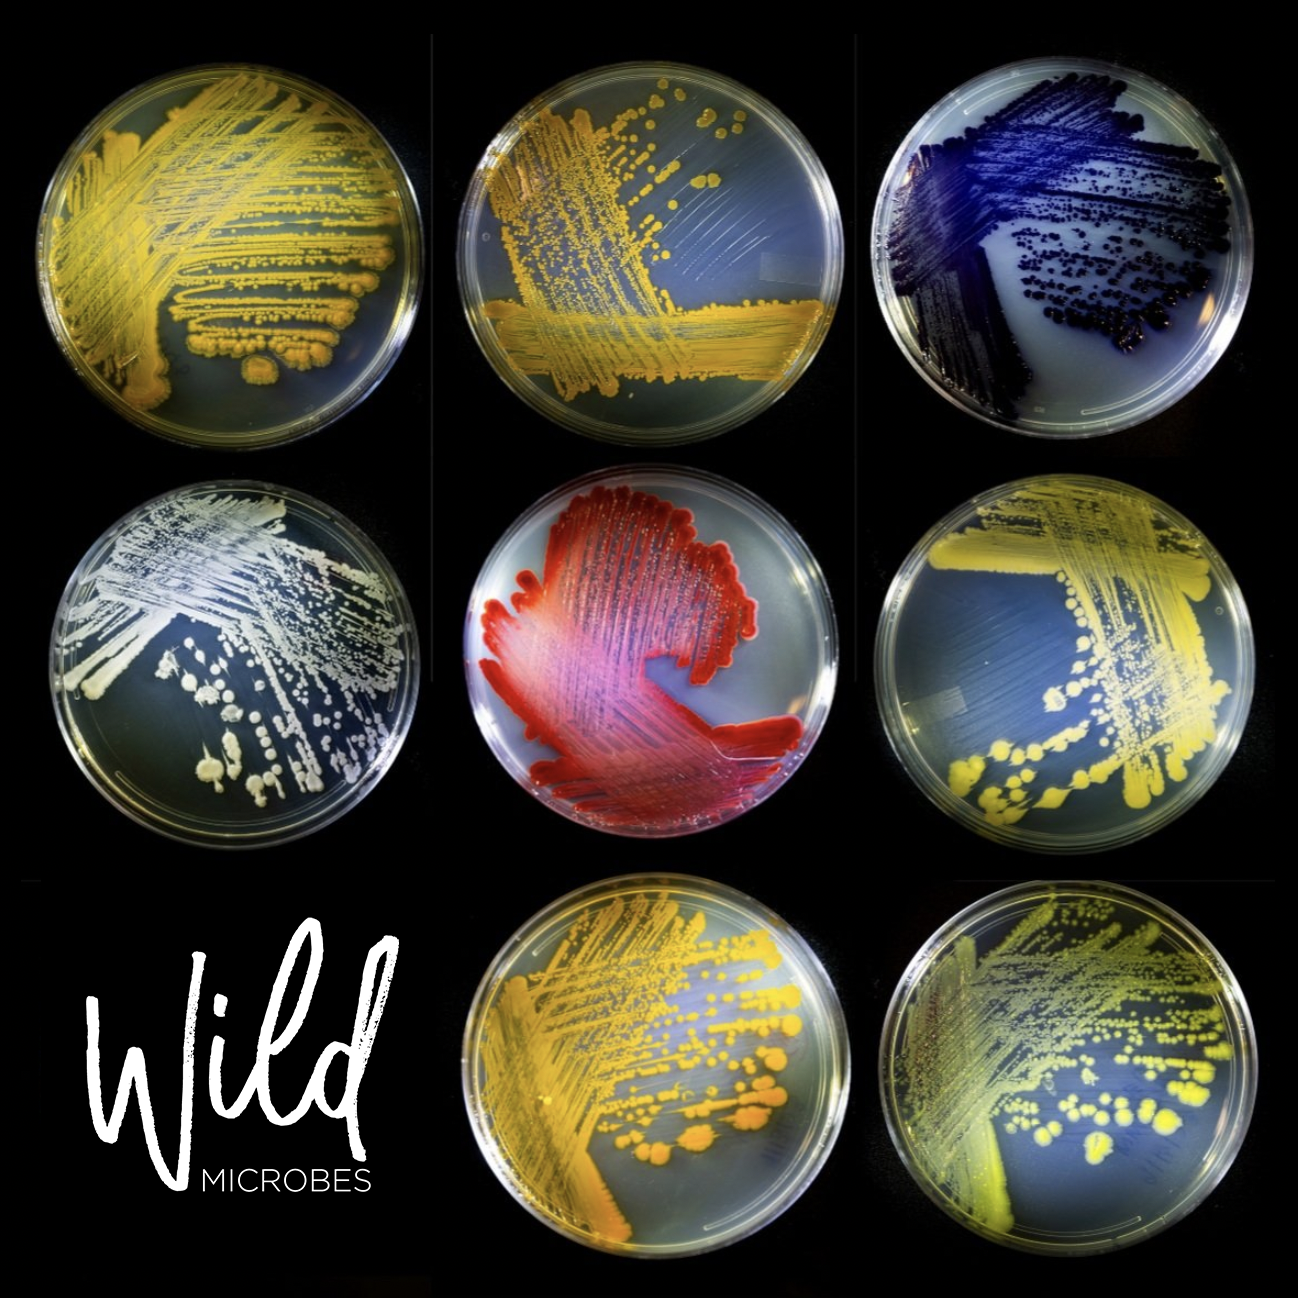

The Bioindustrial Fund
The Bioindustrial Fund
Who We Are
As scientists and entrepreneurs ourselves, we speak the same language as the founders we back.
We are in a "Cambrian Explosion" of deep tech company formation. Juniper invests in breakthrough technologies that redefine trillion-dollar markets while solving humanity’s most difficult sustainability challenges. Previously, we were known as Climate Capital Bio.
Most early stage investors are not specialists in frontier science. We are.
60% of all physical inputs to the global economy can, and will, be produced by engineered biology, allowing us to finally kick our petrochemical dependency.
INFRASTRUCTURE
Wild Microbes
VISIT SITE ︎︎︎
FOOD & AGRICULTURE
California Cultured

California Cultured radically reduces greenhouse gas emissions and addresses deforestation and human rights issues that plague the cocoa and coffee industries by being the first and only company that makes real chocolate using cell-based agriculture, and one of the first companies to produce cell-based coffee.
VISIT SITE ︎︎︎
CHEMICALS & MATERIALS
Matereal

Matereal leverages advanced chemistry and AI to decarbonize and detoxify plastics. Its flagship platform, Polaris™, is a renewable, biobased alternative to traditional polyurethane, offering the same versatility and durability without petrochemicals or isocyanates.
VISIT SITE ︎︎︎

Juniper Zero is our non-profit incubator for founders building the biotech solutions needed for the world to reach Net Zero. We prepare scientists and first time founders to become extraordinary entrepreneurs by providing access to educational resources, mentors, and capital networks to participating companies entirely for free.